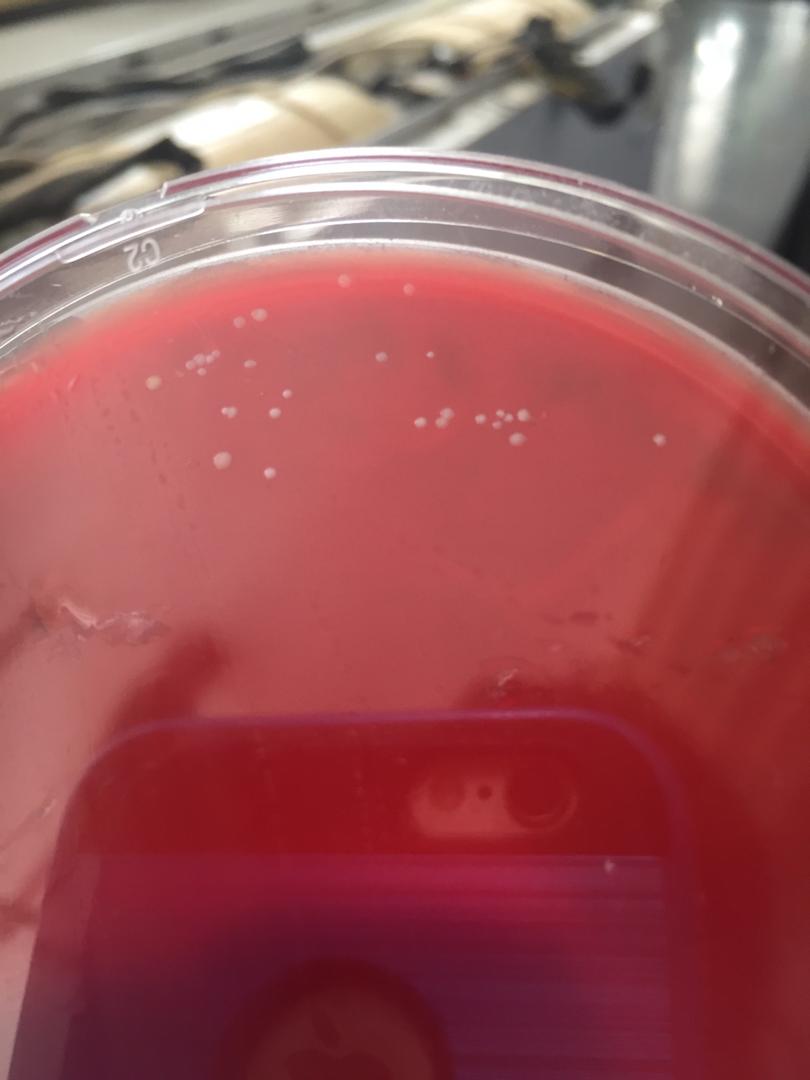
featured

Alejandra Narváez (42)
24 years old Venezuelan girl.
264 followers91 posts44 following4 HP
Blacklisted UsersMuted UsersFollowed BlacklistsFollowed Muted Lists
Blacklisted UsersMuted UsersFollowed BlacklistsFollowed Muted Lists
Venezuela Joined February 2018 Active 6 years ago